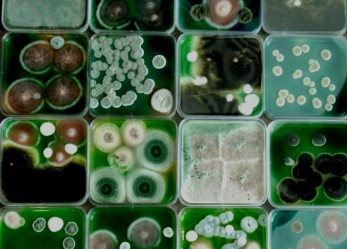
Fiera della Scienza di Google 2015

News concorsi culturali
Partecipation awards: la tua esperienza di volontariato in un video
Concorso video partecipation awards
Leggi tuttoIl Mediterranean youth water hackathon per la sostenibilità
Vuoi mettere il tuo spirito imprenditoriale al servizio di sostenibilità e innovazione? Se hai meno di 35 anni puoi partecipare allo Youth Water Hackathon dell’Unione per il Mediterraneo. Candidati entro il 1° dicembre 2024.
Leggi tuttoUn bando under 35 per far conoscere la tua arte all’estero
Fai arte e sei under 35? Con il bando Per chi crea del Ministero della cultura puoi far conoscere la tua arte anche all’estero. Partecipa entro il 31 ottobre 2024.
Leggi tuttoCrea la tua maglietta per il T-shirt design contest Time To Move
Ti piace disegnare e viaggiare? Crea la tua maglietta per la campagna Time To Move 2025. Hai tempo fino al 31 ottobre 2024.
Leggi tuttoFai fruttare le tue competenze per il Pool of young journalists in Europe
Sogni di fare giornalismo e vuoi mettere a frutto le tue competenze per i giovani in Europa? Partecipa al Pool of young journalists in Europe. Hai tempo fino al 31 ottobre 2024.
Leggi tuttoParti anche tu con DiscoverEU!
Ti piace viaggiare, esplorare, scoprire? Se hai 18 anni: partecipa a DiscoverEU e vinci un pass per girare tutta l’Europa in treno! Candidati entro il 16 ottobre 2024.
Leggi tuttoTorna il concorso europeo per giovani traduttrici e traduttori!
Hai 17 anni e ti piace tradurre? Partecipa al concorso di traduzione europeo Juvenes Translatores entro il 15 ottobre 2024.
Leggi tuttoFotografa Brescia per l’Agenzia europea dell’ambiente
Ami Brescia e ti piace fare fotografie? Partecipa al concorso internazionale dell’Agenzia europea dell’ambiente Urban treasures. Hai tempo fino al 1° ottobre 2024.
Leggi tuttoLa tua creatività per i diritti umani
Ti stanno a cuore i diritti umani? Dillo con una foto o con un video e partecipa al concorso Human Rights: Camera, Action! Hai tempo fino al 31 luglio 2024.
Leggi tuttoVola a New York con il tuo progetto per l’ambiente
Gira un video del tuo progetto per l’ambiente e vinci un viaggio a New York. Partecipa entro il 31 luglio 2024.
Leggi tuttoCon Eures: un viaggio a Bratislava e il lavoro dei tuoi sogni in Europa
Come ti aiuta Eures a cercare lavoro in Europa? Raccontalo in 1 video e vola a Bratislava. PARTECIPA ENTRO IL 5 luglio 2024.
Leggi tuttoCrea una locandina per uno spettacolo teatrale!
Scadenza: 26 Maggio 2024 Se sei un giovane artista e hai voglia di metterti alla prova
Leggi tuttoConcorso “BookTuberPrize 2024”
Sai chi sono i booktuber? I booktuber leggono libri, ne parlano e li condividono; fanno conoscere
Leggi tuttoStudenti delle scuole superiori al Cern di Ginevra
Termine per candidarti: 10 aprile 2024. Sogni di fare la/o scienziata/o? Vuoi sapere cosa vuol dire Leggi tuttoYoung champions of the Earth 2024
Termine per candidarti: 5 aprile 2024. Hai a cuore la natura e vuoi combattere per la Leggi tuttoIl tuo video per votare
Termine per candidarti: 17 marzo 2024. Ti appassionano le arti visive? Hai tra i 18 e Leggi tuttoParti in tournée con la JM Jazz World Orchestra
Termine per candidarti: 8 marzo 2024. Ami il jazz e canti o suoni il il basso, Leggi tuttoProteggi gli oceani con l’arte
Termine per candidarti: 4 marzo 2024. Vuoi proteggere gli oceani con l'arte? Se hai tra gli Leggi tuttoPremio europeo per chi unisce pratica artistica e tecnologia
Termine per candidarti: 1° marzo 2024. Sei un artista e ti piace unire pratica artistica e Leggi tuttoUnisciti ai Young European Heritage Makers
Termine per candidarti: 28 febbraio 2024. Young European Heritage Makers. Giovani creatori di patrimonio europeo. Leggi tuttoIl tuo progetto per la democrazia europea
Termine per candidarti: 12 febbraio 2024. Hai un'idea per sostenere la democrazia in Europa e promuovere Leggi tuttoPremio internazionale per giovani ceramisti
Termine per candidarti: 27 febbraio 2024. Lavori la ceramica? Partecipa al Premio internazionale giovani talenti per Leggi tuttoIl nostro patrimonio culturale a scuola
Termine per candidarti: 18 febbraio 2024. Ti affascina il teatro romano in centro a Brescia? O Leggi tuttoBando per giovani artisti
Sei un’artista? ti piacerebbe che la tua opera fosse esposta presso il Padiglione Venezia, ai Giardini
Leggi tuttoYoung entrepreneurs challenge 2024
Termine per candidarti: 19 gennaio 2024. Hai un'idea imprenditoriale innovativa, basata sulla tecnologia, capace di risolvere Leggi tuttoCome la natura può aiutarci?
Termine per candidarti: 18 gennaio 2024. Come può la natura aiutarci a raggiungere nella nostra Leggi tuttoScrivi la tua esperienza all’estero e vinci nuovi viaggi
Termine per candidarti: 7 gennaio 2024. Hai fatto un'esperienza all'estero? Hai voglia di raccontarla e ispirare Leggi tuttoSe fossi tu il presidente del Parlamento europeo…
Termine per candidarti: 30 dicembre 2023. Se fossi tu il presidente del Parlamento europeo cosa faresti Leggi tuttoRompiamo le barriere con le nostre foto
Termine per candidarti: 15 dicembre 2023. Vedi ancora troppe barriere intorno a te? Contribuisci ad Leggi tuttoCondividi le tue competenze
Termine per candidarti: 15 dicembre 2023. Stai facendo un percorso di istruzione e formazione professionale? Hai Leggi tuttoIl vostro video per un viaggio studio a Bruxelles
Termine per candidarti: 13 dicembre 2023. Stai facendo l'ultimo biennio di scuola secondaria? Ti piace girare Leggi tuttoIl tuo prodotto digitale per l’Agenda 2023
Termine per candidarti: 10 novembre 2023. Hai ideato un prodotto che unisce innovazione digitale e impatto Leggi tuttoLa tua visione dell’Europa del futuro
Termine per candidarti: 31 ottobre 2023. Hai tra 13 e 19 anni? Vuoi condividere la tua Leggi tuttoPremi Bauhaus europeo per under 30
Termine per candidarti: 10 novembre 2023. Hai in mente un progetto o un concetto innovativo per Leggi tuttoLa tua creatività per viaggiare in Europa!
Termine per candidarti: 31 ottobre 2023. La creatività è il tuo forte e viaggiare la tua Leggi tuttoTorna Juvenes Translatores!
Termine per candidarti: 16 ottobre 2023. Vuoi sapere cosa significa tradurre per professione? Partecipa al Juvenes Leggi tuttoConcorso fotografico ZeroWaste PIX – 2023
Termine per candidarti: 3 ottobre 2023. Ti piace fotografare e vuoi contribuire a alternative di consumo sostenibili? Leggi tuttoPremio per giovani imprenditori universitari
Termine per partecipare: 1° agosto 2023. La Fishbowl Challenge è una piattaforma di lancio per giovani Leggi tuttoPremio per giovani inventori
Termine per la candidatura: 19 luglio 2023 Studi o hai studiato Design o Ingegneria? Partecipa al Leggi tuttoDigital Education Hackathon 2023
Ti interessa l'educazione digitale? Partecipa a Digital Education Hackathon, o DigiEduHack 2023! Dal 6 al 13 Leggi tuttoConcorso video per under25
Termine per la partecipazione: 30 giugno 2023. Hai meno di 25 anni? Vuoi contribuire al cambiamento Leggi tuttoPlurals Talents U19 premia la tua arte
Termine per la partecipazione: 21 giugno 2023. Hai tra 13 e 18 anni? Sei appassionato di Leggi tuttoScrivi il futuro della Terra
Termine per la partecipazione: 13 giugno 2023. Ti piace scrivere e ti sta a cuore il Leggi tuttoPremio per una carriera diplomatica
Termine per la partecipazione: 30 giugno 2023. Sei impegnato nella cooperazione internazionale in vista di una convivenza Leggi tuttoOlimpiadi delle scienze climatiche: mettiti in gioco per il pianeta
Termine di partecipazione: 10 giugno 2023. Hai meno di 25 anni e hai in mente una Leggi tuttoConcorso di scrittura per la pace e lo sviluppo sostenibile
Termine per la candidatura: 15 giugno 2023. Hai meno di 25 anni e ti piace scrivere? Leggi tuttoPremio internazionale per cortometraggi
Scadenza: 12 giugno 2023 Sogni di fare il regista? Partecipa al concorso internazionale per cortometraggi DepicT! Leggi tuttoBorse di studio Women photograph
Termine per partecipare: 15 maggio 2023. Per fotografi e aspiranti fotografi 2 borse di studio: Women Leggi tuttoInventa il tuo supereroe
Termine di partecipazione: 30 aprile 2023. Hai meno di 16 anni e ti piace immaginare storie? Leggi tuttoPremio europeo per giovani giornalisti
Termine di scadenza: 28 aprile 2023. Il Premio Lorenzo Natali premia giovani giornalisti! Invia il tuo
Leggi tuttoTime to change your tune
Termine di partecipazione: 30 aprile 2023. Se ti piace scrivere partecipa al Concorso internazionale Time to Leggi tuttoLe tue idee per cambiare il mondo
Termine di partecipazione: 31 marzo 2023. Vuoi cambiare il mondo e farne uno spazio sostenibile? Condividi le Leggi tuttoS+T+ARTS, premio europeo per tecnologia, scienza e arte
Termine di partecipazione: 3 marzo 2023. Il Premio S+T+ARTS (Science Technology Arts) della Commissione europea premia alleanze Leggi tuttoUn premio per la salvezza del pianeta
Termine di partecipazione: 1° marzo 2023. Chi sta salvando il pianeta? Hai tra 13 e 19 Leggi tuttoPremio per la difesa dei diritti dei bambini
Termine di scadenza: 1° marzo 2023. Hai tra i 12 e i 18 anni? Vuoi contribuire Leggi tuttoScrivi un radiodramma per la BBC
Termine di partecipazione: 12 febbraio 2023. Ti piace scrivere? Ti piacerebbe scrivere per la radio? Partecipa Leggi tuttoConcorso europeo per giovani scienziati
Termine di partecipazione: 10 febbraio 2023. Hai meno di 21 anni e ti piacciono le scienze? Leggi tuttoPremio europeo Carlo Magno della gioventù
Termine di partecipazione: 2 febbraio 2023. Hai tra 16 e 30 anni? Hai in mente un
Leggi tuttoPremio per start up
Termine di partecipazione: 20 gennaio 2023. Hai tra i 16 e i 25 anni? Hai un’idea
Leggi tuttoYoung entrepreneurs challenge 2023
Termine di partecipazione: 20 gennaio 2023. La Young entrepreneurs challenge ti invita a presentare un video
Leggi tuttoRaccontaEstero
Termine di partecipazione: 8 gennaio 2023. Sei stato all’estero e vuoi condividere la tua esperienza? Vuoi
Leggi tuttoConcorso di scrittura
Termine di partecipazione: 25 novembre 2022. Ti piace scrivere e usare le nuove tecnologie? Partecipa al
Leggi tuttoOra di muoversi
Termine di partecipazione: 31 ottobre 2022. Torna Time To Move! Hai tra i 13 e i 30
Leggi tuttoCos’è per te l’Europa?
Termine di partecipazione: 6 novembre 2022. Cos’è per te l’Europa? Se hai una risposta partecipa al
Leggi tuttoViaggia e condividi
Termine di partecipazione: 16 ottobre 2022. Vuoi creare contenuti per il web e ti piace viaggiare?
Leggi tuttoUn concorso per studentesse/i di Giurisprudenza
Termine di partecipazione: 30 ottobre 2022. Studi Giurisprudenza? Vuoi acquisire esperienza nel settore? Partecipa al Concorso
Leggi tuttoConcorso fotografico She shapes biodiversity
Termine di partecipazione: 24 ottobre 2022. Il concorso fotografico She shapes biodiversity ti invita a fotografare i
Leggi tuttoTraduci e vola a Bruxelles
Termine di partecipazione: 20 ottobre 2022. Juvenes Translatores è il famoso concorso di traduzione per le
Leggi tuttoCortometraggi sulla dignità umana e sulla salute mentale
Termine di partecipazione: 10 ottobre 2022. Il Knowmad short film festival (KSFF) invita registi dilettanti e
Leggi tuttoPremi per giovani inventori
Termine di partecipazione: 3 ottobre 2022. Hai meno di 30 anni e un’idea per risolvere uno dei
Leggi tuttoUn premio per giovani fotografi viaggiatori
Termine di partecipazione: 25 ottobre 2022. Ti piace viaggiare? Ti piace fotografare? Se hai massimo 18
Leggi tuttoLe tue foto DiscoverEU per #3miliardiDiAlberi
Termine di partecipazione: 15 settembre, 15 ottobre 2022. Hai fatto un viaggio con DiscoverEU nel 2018,
Leggi tuttoLa tua idea per i 17 Obiettivi di sviluppo sostenibile
Termine di partecipazione: 15 settembre 2022. Hai più di 13 anni? Hai un’idea innovativa per realizzare
Leggi tuttoTutti gli eventi per la Giornata europea delle lingue
Quando: 26 settembre 2022. Il 26 settembre è la Giornata europea delle lingue. Molti sono gli
Leggi tuttoConcorso internazionale per le megalopoli
Termine di partecipazione: 15 ottobre 2022. L’organizzazione non governativa francese MegaCities-ShortDocs ospita un concorso internazionale di ShortDocs (brevi
Leggi tuttoFotografa la natura per l’Agenzia europea dell’ambiente
Termine di partecipazione: 1° ottobre 2022. Ti piace fotografare e ti sta a cuore l’ambiente? Partecipa
Leggi tuttoPremio per startup e artisti
Termine di partecipazione: 30 agosto 2022. Il concorso di MediaFutures seleziona startup e artisti con idee innovative,
Leggi tuttoGiovani fotografe/i per l’ambiente
Termine di partecipazione: 31 agosto 2022. Ti piace fotografare e vuoi contribuire a uno sviluppo sostenibile?
Leggi tuttoPremio per laureate/i in aviazione
Termine di partecipazione: 4 settembre 2022. Hai studiato gestione del traffico aereo (air traffic management ATM)
Leggi tuttoDisegna una vignetta per il futuro della Terra
Termine di partecipazione: 20 agosto 2022. Ti piace disegnare e ti sta a cuore il futuro
Leggi tuttoLa tua creatività per la bioeconomia
Termine di partecipazione: 15 agosto 2022. Hai tra i 14 e i 35 anni, sei creativa/o e
Leggi tuttoLa tua soluzione per il clima
Termine di partecipazione: 10 agosto 2022. Hai tra i 12 e i 25 anni e ti sta
Leggi tuttoPremi europei per giovani donne innovatrici
Termine di partecipazione: 18 agosto 2022. Con l’EU Prize for women innovators la Commissione europea premia
Leggi tuttoGira un video per la Giornata europea delle lingue
Termine di partecipazione: 12 agosto 2022. Il 26 settembre la Commissione europea celebra la Giornata europea
Leggi tuttoFinanziamenti per idee innovative
Termine di partecipazione: non c’è una scadenza: le domande di partecipazione sono esaminate ogni 3 mesi
Leggi tuttoPremi per giovani musicisti
Termine di partecipazione: 20 giugno 2022. L’associazione non governativa belga Jeunesses musicales international, fondata nel 1945
Leggi tuttoPremi per video su immigrazione e diversità
Termine di partecipazione: 17 giugno 2022. Hai meno di 25 anni, ti interessi di immigrazione e
Leggi tuttoConcorso internazionale per cortometraggi
Termine di partecipazione: 13 giugno 2022. Ti piace girare e filmare? Partecipa al concorso internazionale per
Leggi tuttoConcorso internazionale di componimento per giovani
Termine di partecipazione: 15 giugno 2022. Come ogni anno The Goi peace foundation, lancia un concorso
Leggi tuttoPremio per giovani economisti
Termine di partecipazione: 6 giugno 2022. L’Organizzazione mondiale del commercio (OMC o WTO) ha lanciato l’Essay
Leggi tuttoConcorso per la sostenibilità
Termine di partecipazione: 31 marzo 2022. Hai tra i 10 e i 24 anni e ti stanno
Leggi tuttoPremio per giornalisti emergenti
Termine di partecipazione: 31 marzo 2022. Sei un/a giornalista e hai meno di 30? Partecipa al Premio
Leggi tuttoLe porte d’Europa per scuole secondarie di II grado
Termine di partecipazione: 30 marzo 2022. Porte d’Europa è un concorso per le ultime 3 classi
Leggi tuttoPer studentesse e studenti delle scuole secondarie di II grado
Termine di partecipazione: 8 marzo 2022. Studentesse e studenti delle scuole secondarie di II grado: il
Leggi tuttoPremi per produzioni multimediali per l’istruzione
Termine di partecipazione: 17 marzo 2022. Hai creato video, audio, simulazioni, app AR/VR/XR, podcast, vlog, animazioni
Leggi tuttoUna competizione globale per il Made in Italy
Termine di partecipazione: 28 febbraio 2022. Il Financial Times e Il Sole 24 Ore cercano 100 talenti
Leggi tuttoPremio Young European of the year 2022
Termine di partecipazione: 27 febbraio 2022. La fondazione Heinz-Schwarzkopf favorisce l’acquisizione da parte dei giovani di
Leggi tuttoPremi per giovani imprenditori sociali
Termine di partecipazione: 24 febbraio 2022. Il Social Innovation Tournament dell’European investment bank riconosce e sostiene
Leggi tuttoPremio S+T+ARTS per opere d’arte, scienza e tecnologia
Termine di partecipazione: 2 marzo 2022. Il Premio S+T+ARTS (Science Technology Arts) della Commissione europea premia
Leggi tuttoPremi per progetti sostenibili, inclusivi e belli
Termine di partecipazione: 28 febbraio 2022. La Commissione europea ha lanciato l’iniziativa New european Bauhaus per
Leggi tuttoUn premio per i diritti dei bambini
Termine di scadenza: 1° marzo 2022. Come ogni anno torna l’International children’s peace prize della fondazione
Leggi tuttoScuole superiori per lo sviluppo sostenibile
Termine di partecipazione: 28 febbraio 2022. È aperto alle scuole superiori pubbliche e private (istituti di istruzione
Leggi tuttoUn’open call per giovani musicisti e teatranti
Termine di partecipazione: 16 febbraio 2022. Hai meno di 30 anni e sei un’/un artista o
Leggi tuttoScrivi un progetto per l’Europa
Termine di scadenza: 13 febbraio 2022. Partecipa anche tu al Concorso europeo Carlo Magno di Aquisgrana
Leggi tuttoGira un video sull’efficienza energetica
Termine di partecipazione: 15 febbraio 2022. Hai tra i 12 e i 15 anni? Vuoi fare
Leggi tuttoRispondi a Eurodesk e vinci una macchina fotografica
Termine di partecipazione: 16 gennaio 2022. Hai tra i 13 e i 35 anni? Partecipa al
Leggi tuttoGira un video per l’Unione europea
Termine di partecipazione: 22 febbraio 2022. Hai tra i 16 e i 26 anni? Risiedi in
Leggi tuttoDisegno e creatività per la Giornata europea delle lingue
Termine di partecipazione: 31 dicembre 2021. Ti piace disegnare? Sei creativa/o? Partecipa al concorso per il
Leggi tuttoLa tua creatività per i diritti sociali dell’Europa
Termine di partecipazione: 19 dicembre 2021. Hai tra i 18 e i 30 anni? Vivi nell’Unione
Leggi tuttoFotografie per un futuro più pulito
Termine di partecipazione: 30 novembre 2021. Il CER – Community of european railway and infrastructure companies
Leggi tuttoSport e fotografia per l’uguaglianza e l’inclusione
Termine di partecipazione: 30 novembre 2021. Hai tra i 18 e i 35 anni? Sei appassionata/o di
Leggi tuttoConcorso fotografico internazionale
Termine di partecipazione: 30 novembre 2021. È aperto il 19° concorso fotografico annuale rivista Smithsonian, dell’istituto
Leggi tuttoFotografa la tua storia
Termine di partecipazione: 21 novembre 2021. Quest’anno il concorso fotografico sulla formazione professionale del Cedefop, Centro europeo
Leggi tuttoIllustra la tua scoperta dell’Europa e vinci 1 biglietto Interrail
Termine di partecipazione: 1° novembre 2021. Hai tra i 13 anni e e i 30 anni?
Leggi tuttoDiscoverEu: il pass per esplorare l’Europa
Termine per la partecipazione: 26 ottobre 2021. Hai 18 anni, sei cittadina/o europea/o e hai voglia
Leggi tuttoIl tuo progetto di comunicazione innovativa per l’efficienza energetica
Termine di partecipazione: 15 ottobre 2021. Vuoi partecipare alla trasformazione del panorama energetico europeo e mondiale?
Leggi tuttoUn premio per chi studierà o ha studiato all’estero
Termine di partecipazione: 13 ottobre 2021. Hai studiato all’estero? Vorresti studiare all’estero? Il concorso Travel video
Leggi tuttoUn video per i tuoi diritti
Termine di partecipazione: 15 ottobre 2021. Hai tra i 10 ai 17 anni e vuoi dire
Leggi tuttoPremio europeo per giovani traduttrici e traduttori
Termine di partecipazione: 20 ottobre 2021. Il concorso europeo per le scuole Juvenes Translatores premia 28 giovani
Leggi tuttoConcorso per un’istruzione innovativa, inclusiva e di qualità
Termine di partecipazione: 31 ottobre 2021. Il concorso internazionale Global junior challenge premia i progetti che
Leggi tuttoIn treno attraverso l’Europa
Termine per la partecipazione: 8 ottobre 2021. Il 2021 è l’Anno europeo delle ferrovie. Il Connecting
Leggi tuttoHackaton per appassionati di spazio
Quando: 29 settembre, 2 e 3 ottobre 2021. Il NASA international space apps challenge è un
Leggi tuttoPremio europeo per inchieste giornalistiche
Termine per la partecipazione: 1 settembre 2021. Il premio del Parlamento europeo Daphne Caruana Galizia prize
Leggi tuttoSuonare per migliaia di giovani europei
Termine per la partecipazione: 1 settembre 2021. Il concorso European emerging bands invitano le band europee
Leggi tuttoProgetti per una scuola innovativa e inclusiva
Termine per la partecipazione: 31 luglio 2021. Il concorso internazionale Global junior challenge premia i progetti che
Leggi tuttoGira un video per il disarmo
Termine per la partecipazione: 15 luglio 2021. What if – Spesterra youth video challenge è un concorso
Leggi tuttoSquadre europee per il futuro d’Europa
Termine per la partecipazione: 2 luglio 2021. L’hackathon #Insiemeper #ilFuturoèTuo del Web marketing festival ti invita
Leggi tuttoFotografa l’ambiente e vinci una Nikon
Termine per la partecipazione: 14 agosto 2021. Hai tra 18 e 21 anni? Ti piace fotografare
Leggi tuttoFotografa il cambiamento climatico
Termine per la partecipazione: 1 agosto 2021. Il clima sta cambiando. Il concorso fotografico Climate change
Leggi tuttoPremi per la transizione verso l’energia pulita in Europa
Termine per la partecipazione: 2 luglio 2021. Partecipa agli EU Sustainable Energy Awards e presenta un’attività,
Leggi tuttoPremi per startup di innovazione sostenibile
Termine per la partecipazione: 30 giugno 2021. Ogni anno il concorso Innovation village award premia tecnologie, soluzioni o
Leggi tuttoPremi internazionali per la sostenibilità
Termine per la partecipazione: 30 giugno 2021. Studi o sei laureato in Design o Ingegneria? O
Leggi tuttoDisegno e sport per i rifugiati
Termine per la partecipazione: 25 giugno 2021. Il tema di quest’anno del concorso Youth with refugees
Leggi tuttoPremio europeo per donne innovatrici
Termine per la partecipazione: 30 giugno 2021. Il EU Prize for women innovators della Commissione europea premia
Leggi tuttoGira un video su immigrazione e diversità, inclusione sociale e prevenzione alla xenofobia
Termine per la partecipazione: 18 giugno 2021. Come ogni anno, il videofestival internazionale per i giovani
Leggi tuttoDall’idea all’impresa in 6 mesi per un cambiamento sociale
Termine per la partecipazione: 1° luglio 2021. Fishbowl challenge è un programma per supportare giovani imprenditori
Leggi tuttoUn concorso per una cittadinanza euromediterranea condivisa
Termine per la partecipazione: 25 giugno 2021. Sea of words – Giovani e mobilità: verso una cittadinanza
Leggi tuttoYoung audiences music award premia la creatività musicale
Termine per la partecipazione: 20 giugno 2021. YAM (Young audiences music)awards premia la creatività e l’innovazione
Leggi tuttoPer la conservazione e il ripristino degli ecosistemi terrestri e costieri
Termine per la partecipazione: 15 giugno 2021. #GenerationRestoration youth challenge premia soluzioni per la conservazione e
Leggi tuttoScrivi un saggio sulla vita per uno sviluppo sostenibile
Termine per la partecipazione: 15 giugno 2021. Come ogni anno, la fondazione giapponese Goi Peace ti invita
Leggi tuttoArchitettura e design per lo sviluppo sostenibile
Termine per la partecipazione: 3 giugno 2021. jumpthegap®, il concorso internazionale di design di Roca, premia
Leggi tuttoSostenibilità, bellezza e inclusione per il New European Bauhaus 2021
Termine per la partecipazione: 31 maggio 2021. Il New European Bauhaus interpella artisti, attivisti, designer, architetti,
Leggi tuttoPromuovi lo sviluppo e la cooperazione nel Mediterraneo
Termine per la partecipazione: 31 maggio 2021. Rome MED Mediterranean dialogues 2021 annuncia il Youth forum
Leggi tuttoUn concorso per giovani economisti
Termine per la partecipazione: 30 maggio 2021. Stai facendo un dottorato in Economia o finanza e
Leggi tuttoFai il quiz europeo: in palio per te un iPad Pro 11
Termine per la partecipazione: 23 maggio 2021. La Banca centrale europea (BCE) lancia il concorso #EuropeDay ECB-QuizDuel,
Leggi tuttoAutoritratti per l’energia
Termine per la partecipazione: 21 aprile 2021. Il concorso Energy self portraits vuole raccogliere una serie di
Leggi tuttoPer cambiare e innovare società, ambiente o benessere sociale
Termine per la partecipazione: 26 aprile 2021. La Call for Impactability – dall’unione di impact e
Leggi tuttoGiovani talenti per l’Italia, l’Europa e il mondo
Termine per la partecipazione: 15 aprile 2021. Il Premio dell’Istituto affari internazionali Giovani talenti per l’Italia,
Leggi tuttoPremio per insegnanti di inglese
Termine per la partecipazione: 21 marzo 2021. Il British Council premia l’innovazione nell’insegnamento e nell’apprendimento della
Leggi tuttoPionieri per lo sviluppo sostenibile
Termine per la partecipazione: 15 marzo 2021. Lavori per una società partecipante o firmataria del Global
Leggi tuttoGira un video per partecipare alla ripresa
Termine per la partecipazione: 15 marzo 2021. Hai tra i 18 e i 35 anni? Pensi
Leggi tuttoScrivi un saggio per infrastrutture resilienti
Termine per la partecipazione: 8 marzo 2021. Il Coalition for disaster resilient infrastructure (CDRI) lancia il concorso
Leggi tuttoManda il tuo progetto di sviluppo sostenibile
Termine per la partecipazione: 31 marzo 2021. Frequenti la scuola secondaria di II grado? Ti sta
Leggi tuttoIdee fresche contro il riscaldamento globale
Termine per la partecipazione: 28 maggio 2021 (la scadenza è stata prorogata). Assocalzaturifici Italiani e il
Leggi tuttoConcorso di fumetti per la parità di genere
Termine per la partecipazione: 14 marzo 2021. Hai tra i 18 e i 25 anni e
Leggi tuttoIl torneo della Banca europea per gli investimenti
Termine per la partecipazione: 3 marzo 2021. Il Torneo dell’innovazione sociale premia progetti di impatto sociale,
Leggi tuttoS+T+ARTS il concorso che premia arte e tecnologia
Termine per la partecipazione: 3 marzo 2021. Il concorso S+T+ARTS (science, technology, arts) premia opere artistiche
Leggi tuttoProposte per una serie tv crime
Termine per la partecipazione: 1° marzo 2021. Il concorso DETECt crime series contest invita a presentare
Leggi tuttoUn concorso europeo sull’Europa
Termine per la partecipazione: 22 febbraio 2021. Se hai tra i 16 e i 30 anni e
Leggi tuttoUn sostegno per la tua attività artistica all’estero
Termine per presentare la domanda: 19 marzo 2021. Fai musica, teatro, danza o circo contemporaneo? Hai
Leggi tuttoConcorso per le scuole secondarie di 2° grado
Termine per la partecipazione: 22 gennaio 2021. Sei una studentessa o uno studente italiana/o della scuola
Leggi tuttoFilm in polacco, finlandese, tedesco, greco, spagnolo e… un concorso di fumetti
Quando: dal 12 al 18 dicembre 2020. Ti piace il cinema contemporaneo? Sei curioso di conoscere
Leggi tuttoIn arrivo il nuovo programma Erasmus+
Hai fatto l’Erasmus? Sei membro di una comunità eTwinning? Hai lavorato a un progetto per l’educazione
Leggi tuttoProgettare il futuro con giovani europei e canadesi
Termine per la partecipazione: 1° dicembre 2020. Hai tra i 18 e i 30 anni e
Leggi tuttoEuropean press prize per giornalisti e blogger
Termine per la partecipazione: 11 dicembre 2020. Sono aperte le iscrizioni per il European press prize. Puoi
Leggi tuttoUn concorso fotografico per vincere un corso di fotogiornalismo
Termine per la partecipazione: 28 ottobre 2020. Il concorso fotografico vuole far luce sull’impatto della pandemia
Leggi tuttoDisegna una T-shirt per la mobilità europea
Dal 1° al 31 ottobre 2020 parte la campagna Time to move. Eurodesk realizzerà iniziative online per
Leggi tuttoValorizziamo la biodiversità alimentare
Termine per la partecipazione: 7 ottobre 2020. Food factory-4-us è un concorso internazionale per valorizzare la
Leggi tuttoPresenta la Corea agli italiani
Termine per la partecipazione: 12 ottobre 2020. Conosci la Corea e la sua cultura hai voglia
Leggi tuttoConcorso di scrittura sullo sviluppo sostenibile
Termine per la partecipazione: 30 settembre 2020. Hai tra i 14 e i 19 anni e hai
Leggi tuttoIl mio momento magico con il Corpo europeo di solidarietà
Termine per la partecipazione: 31 ottobre 2020. Hai tra i 18 e i 31 anni e
Leggi tuttoRediscover nature
Termine per la partecipazione: 30 settembre 2020. Anche quest’anno è arrivato il momento del concorso fotografico
Leggi tuttoGiovani e imprenditoria
Termine per la partecipazione: 18 settembre 2020. Di cosa hanno bisogno le PMI – piccole medie
Leggi tuttoConcorso di traduzione online per le scuole secondarie
Termine per la partecipazione: 20 ottobre 2020. Dal 2 settembre 2020 aprono le iscrizioni a Juvenes
Leggi tuttoUpfront! Young european video award
Termine per la partecipazione: 15 novembre 2020. Hai tra i 16 e i 26 anni? Vorresti
Leggi tuttoPremi per le buone pratiche per la valorizzazione del patrimonio culturale
Termine per la partecipazione: 1 ottobre 2020. Il concorso Europa nostra awards 2021 premia progetti per la conservazione
Leggi tuttoViaggio sostenibile in Europa: un ecoconcorso per te
Termine per la partecipazione: 1 ottobre 2020. Hai tra i 16 e i 19 anni e
Leggi tuttoConcorso: la tua storia di mobilità professionale in Europa
Termine per la partecipazione: 15 ottobre 2020. Stai facendo o hai fatto un’esperienza di lavoro/tirocinio/apprendistato con
Leggi tuttoConcorso fotografico Europe together
Termine per la partecipazione: 11 settembre 2020. Hai tra i 18 e i 30 anni? Fotografa
Leggi tuttoCelebra la cooperazione e l’amicizia Italia-Cina
Termine per la partecipazione: 30 agosto 2020. Sei uno studente italiano o cinese? Frequenti la scuola
Leggi tuttoEspandi la tua comfort zone con DiscoverEU
Termine per la partecipazione: ogni mese fino al 28 febbraio 2021. Ti eri candidato a #DiscoverEU
Leggi tuttoPartecipa al design contest per il Marchio europeo di qualità dell’informazione per i giovani
Termine per la partecipazione: 15 luglio 2020. Hai tra i 18 e i 30 anni? Ti
Leggi tuttoIstruzione e formazione professionale: concorso fotografico
Termine per la partecipazione: 30 giugno 2020. Il concorso fotografico Istruzione e formazione professionale: la vostra
Leggi tuttoRacconta i progetti europei nella tua regione
Torna la campagna #EUinmyregion: i beneficiari dei progetti finanziati dall’UE raccontano ai cittadini i traguardi raggiunti.
Leggi tuttoIl tuo Erasmus
Termine per la partecipazione: 15 luglio 2020. Sei iscritto all’università e andrai all’estero con una borsa
Leggi tuttoThe future we want
Termine per la partecipazione: 19 giugno 2020. Ti piace girare video e ti interessi di immigrazione
Leggi tuttoConcorso di cortometraggi… molto corti
Termine per la candidatura: 4 giugno 2020. Partecipa anche tu al concorso internazionale per cortometraggi. Gira
Leggi tuttoLuxembourg Art Prize
Termine per la partecipazione: 30 aprile 2020. Il premio internazionale Luxembourg Art Prize è aperto a
Leggi tuttoConcorso Europa e Giovani 2020
Termine per la partecipazione: 30 aprile 2020. Il concorso Europa e Giovani 2020 è aperto a
Leggi tuttoYoung audiences music awards 2020
Termine per la candidatura: 4 maggio 2020. Come ogni anno Jeunesses musicales international organizza il premio
Leggi tuttoImmagina il 2030 e scriviti una lettera dal futuro
Termine per la candidatura: 15 giugno 2020. Il concorso internazionale di composizione della Goi peace foundation vuole
Leggi tuttoYoung champions of the earth
Termine per la partecipazione: 10 aprile 2020. Vedi opportunità dove gli altri vedono crisi? Vuoi cambiare
Leggi tuttoParole, non muri
Termine per la partecipazione: 31 marzo 2020. Il Muro che scompare è un’installazione in plexiglas nella
Leggi tuttoTu, il pianeta e l’Europa
Termine per la partecipazione: 5 aprile 2020. “Nel corso dell’ultimo anno milioni di giovani in tutto
Leggi tuttoDisegna la tua European solidarity corps t-shirt
Termine per la partecipazione: 31 marzo 2020. Il Corpo europeo di solidarietà chiede ai giovani tra
Leggi tuttoManda le tue immagini per la terra
Termine per la partecipazione: 31 marzo 2020. Il concorso nazionale annuale Immagini per la terra vuole promuovere
Leggi tuttoCercasi giovani illustratori green
Termine per la partecipazione: 6 marzo 2020. Eurodesk e Eryica, l’Agenzia europea per l’informazione e la
Leggi tuttoPremio europeo per la gioventù Carlo Magno 2020
Termine per la partecipazione: 21 febbraio 2020. Come ogni anno dal 2008, il Parlamento europeo invita
Leggi tuttoEmerging bands contest 2020
Termine per la partecipazione: 1 marzo 2020. Yo! Fest è il festival politico annuale della gioventù
Leggi tuttoFai un viaggio di 4 settimane in Europa
Termine per la partecipazione: 15 febbraio 2020. Zis Stiftung für Studienreisen offre a giovani tra i
Leggi tuttoEU Sustainable energy awards anche per under 30
Termine per la partecipazione: 10 febbraio 2020. Il concorso EU Sustainable energy awards premia progetti di
Leggi tuttoMobility First! per artisti e professionisti culturali
Termine per la partecipazione: dal 20 gennaio 2020. Sei artista o professionista culturale e vuoi fare
Leggi tuttoPremio per l’eccellenza nell’insegnamento dell’Unione europea
Termine per la partecipazione: 6 febbraio 2020. Con il Prize for teaching about the European union
Leggi tuttoEuropean statistics competition 2020
Termine per la partecipazione: gennaio 2020. Nel 2019, per la 4ª Giornata europea delle statistiche che
Leggi tuttoPremio Leopoldo Costa per interpreti
Termine per la partecipazione: 23 gennaio 2020. Il Young interpreters award incoraggia la qualità e supporta
Leggi tuttoFotografi del cambiamento climatico
Termine per la partecipazione: 17 febbraio 2020. Il World water day photo contest è dedicato quest’anno al tema
Leggi tutto1 giovane reporter alla Berlinale
Termine di partecipazione: 6 gennaio 2020. Hai meno di 30 anni, sei residente in Italia, sei appassionato
Leggi tutto8 giovani reporter all’European youth event 2020
Termine per la partecipazione: 5 gennaio 2020. Vuoi fare il reporter all’European youth event 2020 dal
Leggi tuttoGiovani delegati al Consiglio d’Europa
Termine per la partecipazione: 3 gennaio 2020. Dal 2014 il Congresso delle autorità locali e regionali
Leggi tuttoYoung European of the year 2020
Termine per la partecipazione: 31 dicembre 2019. La Fondazione Schwarzkopf – in collaborazione con il Forum
Leggi tuttoHai 18 anni? Scopri l’Europa con #DiscoverEU
Termine per la partecipazione: 28 novembre 2019. Torna DiscoverEU: l’iniziativa dell’Unione europea che ti fa viaggiare quasi
Leggi tuttoHai scoperto l’Europa? Partecipa a #DiscoverEU photo&video competition
Termine per la partecipazione: 30 novembre 2019, 31 dicembre 2020… Il concorso #DiscoverEU photo & video #Competition è
Leggi tuttoPoeti solidali
Termine per la partecipazione: 30 novembre 2019. Hai fatto volontariato all’estero con il Corpo europeo di solidarietà e
Leggi tuttoYour Europe, Your Say 2020: Il nostro clima, il nostro futuro!
Termine per la partecipazione: 18 novembre 2019. Siamo alla 10ª edizione di Your Europe, Your Say
Leggi tuttoPremio Unesco per le scuole
Termine per la partecipazione: 14 novembre 2019. Il Premio Unesco per l’uso dell’ICT (Information and communications technology)
Leggi tuttoYour alps! Your future! Your project!
Termine per la partecipazione: 31 ottobre 2019. Hai tra i 16 e i 25 anni e
Leggi tuttoGlobal Junior Challenge 2019
Termine per la partecipazione: 30 ottobre 2019. Il concorso internazionale Global Junior Challenge promosso da Roma Capitale e
Leggi tuttoI giovani e l’Europa
Termine per la partecipazione: 29 ottobre 2019. Il premio Altiero Spinelli – istituito nel 2016 dal
Leggi tuttoTravel Video Contest
Termine per la partecipazione: 15 ottobre 2019. Travel Video Contest è il concorso dell’azienda InternationalStudent per gli
Leggi tuttoJuvenes Translatores per le scuole
Termine per la partecipazione: 20 ottobre 2019. Il concorso di traduzione per le scuole Juvenes Translatores
Leggi tuttoFotografa i diritti
Termine per la partecipazione: 30 settembre 2019. Il concorso fotografico Reclaiming your rights voluto dal Forum
Leggi tuttoPatrimonio culturale: un premio dell’Unione europea
Termine per la partecipazione: 1° ottobre 2019. Il Premio dell’Unione europea per il patrimonio culturale riconosce iniziative
Leggi tuttoQuanta Europa c’è nella tua regione?
Termine per la partecipazione: 18 e 31 agosto 2019. La campagna L’Europa nella mia Regione vuole
Leggi tuttoCosa significa gentilezza per te?
Termine per la partecipazione: 15 giugno 2019. Il tema di quest’anno del Concorso internazionale di componimento per
Leggi tutto#EUSolidarityCorps 2019
Termine per la partecipazione: 31 maggio 2019. Sei stato un volontario del Corpo europeo di solidarietà,
Leggi tutto2019 WTO essay award
Termine per la partecipazione: 31 maggio 2019. Sono aperte le iscrizioni per il premio di componimento
Leggi tutto#EUGreenWeek #MyGreenAction #Let’sCleanUpEurope
Termine per la partecipazione: 10 maggio 2019. Dal 13 al 17 maggio 2019 si terrà la
Leggi tuttoScatta per l’Europa
Termine per la partecipazione: 30 aprile 2019. Cosa significa per te essere europei oggi? Puoi dirlo
Leggi tuttoBe true on the EU!
Termine per la partecipazione: 10 aprile 2019. Il concorso dell’Istituto per gli studi di politica internazionale
Leggi tutto#iameurope
Termine per la partecipazione: 1° aprile 2019. Partecipa al concorso Instagram e puoi vincere un viaggio
Leggi tuttoRacconta la tua esperienza di volontariato
Termine di scadenza: 18 marzo 2019. Hai fatto volontariato all’estero con Erasmus+? Gira un video di
Leggi tuttoEuropa e giovani
Termine per la partecipazione: 22 marzo 2019. Al concorso Europa e giovani 2019 possono partecipare studenti
Leggi tuttoScuole superiori in Germania per esperimenti di fisica
Termine per la partecipazione: 31 marzo 2019. Il concorso del Cern Beamline for Schools (BL4S), alla
Leggi tutto3° #euFilmContest
Termine per la partecipazione: 19 marzo 2019. Partecipa al concorso #euFilmContest e puoi vincere un viaggio
Leggi tuttoSovvenzioni per viaggiare all’estero
Termine per la partecipazione: febbraio 2019. La Fondazione Zis offre a giovani tra i 16 e
Leggi tuttoUn premio per capire l’Europa
Termine di presentazione della domanda: 7 gennaio 2019. Il premio Altiero Spinelli Prize for Outreach è
Leggi tuttoViaggia in Europa con #Discover EU
Termine di presentazione della domanda: 11 dicembre 2018. Sei cittadino dell’Unione europea e hai 18 anni al
Leggi tuttoYour Europe, Your Say: scuole secondarie a Bruxelles
Termine di presentazione della domanda: 28 novembre 2018. Your Europe, Your Say è una sessione plenaria simulata
Leggi tuttoGeneration €uro Students’ Award per scuole secondarie di 2° grado
Termine per la partecipazione: 19 novembre 2018. Generation €uro Students’ Award è un concorso a squadre
Leggi tuttoEU&Me: porta il tuo cinema su grande schermo
Termine per la partecipazione: 31 ottobre 2018. La Commissione europea lancia un concorso per registi fra i
Leggi tuttoTime to move and design
Termine per la partecipazione: 31 ottobre 2018. Eurodesk è la rete ufficiale di Erasmus+ e dà informazioni sulle
Leggi tuttoScuola e traduzione per diventare professionisti
Termine per la presentazione della domanda: 20 ottobre 2018. Anche quest’anno – per la 12ª volta
Leggi tuttoEuropa nostra award e eTwinning per la cultura
Termine per la partecipazione: 1° ottobre 2018 e 15 novembre 2018. Il 2018 è l’Anno Europeo del
Leggi tuttoGlobal Junior Challenge
Termine per la presentazione della domanda: 20 settembre 2019. Il concorso internazionale Global Junior Challenge premia l’uso innovativo
Leggi tuttoGiovani, sport, inclusione sociale e premi
Termine per la presentazione della domanda: 6 settembre 2018. Il concorso #BeInclusive EU Sport Awards della Commissione europea
Leggi tutto#NoCultureNoFuture
Termine per la presentazione della domanda: 3 settembre 2018. La Commissione europea invita a condividere fotografie
Leggi tuttoPmi: scrivi un saggio in inglese
Termine per la presentazione della domanda: 16 settembre 2018. La Commissione europea ti invita a scrivere un
Leggi tutto1° European sustainability award
Termine per la presentazione della domanda: 14 settembre 2018. La Commissione europea ha lanciato la 1°
Leggi tuttoRiprendi energia e diventa reporter
Termine per la presentazione della domanda: 31 agosto 2018. tve è un’organizzazione no profit che crea e
Leggi tuttoIl gioco di ruolo del Parlamentarium per le scuole
Le scuole secondarie e gli studenti di 14-16 anni possono partecipare gratuitamente al gioco di ruolo organizzato
Leggi tuttoGiovani per lo sviluppo del millennio
Termine di presentazione della domanda: 31 luglio 2018. La Fondazione Goi Peace, Stiftung entrepreneurship e Digital
Leggi tuttoLe tue foto esposte a Vienna e in Grecia
Termine per la presentazione della domanda: 15 luglio 2018. Il Centro europeo per lo sviluppo della
Leggi tuttoCosa significa l’Europa per te e come può essere migliorata?
Termine per la presentazione della domanda: 8 luglio 2018. Scrivi un saggio sull’Europa e partecipa al
Leggi tuttoEuropean youth award 2018 per giovani innovativi
Termine di presentazione della domanda: 15 luglio 2018. Il premio European Youth Award (EYA) premia e promuove
Leggi tuttoDepicT! – Can you do it in 90 seconds?
Termine per la presentazione della domanda: 2 luglio 2018. Se ti piace girare video, film, corti ecc.
Leggi tuttoThe change I want to make: bambini e giovani a Tokyo
Termine per la presentazione della domanda: 15 giugno 2018. La Fondazione Goi Peace, partner dell’Unesco, lancia l’International
Leggi tuttoConcorso internazionale di fotografia urbana
Termine di presentazione della domanda: 17 giugno 2018. Per fotografi giovani e meno giovani si è aperta
Leggi tuttoYouth4Regions Competition
Termine della presentazione della domanda: 29 giugno 2018. Per chi studia per diventare giornalista e ha tra i 18
Leggi tuttoFotografi e blogger per l’Europa
Termine di presentazione della domanda: 31 agosto 2018. Il concorso fotografico #Eu in my region ti invita a
Leggi tuttoPremio per giovani cantautori
Termine di presentazione della domanda: 10 aprile 2018. Hai scritto una canzone che tratta in qualche modo
Leggi tuttoAnimus Loci: tracce d’Europa nel cuore d’Italia
Termine della presentazione della domanda: 30 aprile 2018. Il concorso nazionale di narrativa breve Animus Loci:
Leggi tuttoAttraversa l’Europa gratis e raccontala sui social
Termine della presentazione della domanda: 17 aprile 2018. La compagnia inglese Busabout offre a 4 persone un
Leggi tuttoYO!fest2018: giovani musicisti cercasi
Termine della presentazione della domanda: 18 marzo 2018. YO!Fest è il festival per giovani e organizzazioni giovanili europee organizzato
Leggi tuttoI giovani e le scienze 2018
Termine di scadenza per la presentazione della domanda: 10 febbraio 2018 La 30a edizione de I
Leggi tuttoCreatività per l’EYE 2018
Termine di scadenza per la presentazione della domanda: 31 gennaio 2018. In vista dell’European Youth Event EYE2018,
Leggi tuttoPremio europeo Carlo Magno per la gioventù
Termine di scadenza per la presentazione della domanda: 29 gennaio 2018. Il premio europeo Carlo Magno
Leggi tuttoUn tema per proteggere le acque
Termine di presentazione della domanda: 15 dicembre 2017. L’organizzazione del Regno Unito Living Rainforest lancia il concorso di
Leggi tuttoFaces2Hearts
Termine di scadenza per la presentazione della domanda: 13 novembre 2017. Faces2Hearts è un concorso mondiale
Leggi tuttoDiversità culturale per giornalisti, blogger e fotografi non professionisti
Termine di presentazione della domanda: 27 settembre 2017. Il Mediterranean Journalist Award di The Anna Lindh Euro-Mediterranean Foundation è
Leggi tuttoGira un video del tuo soggiorno (immaginato) all’estero
Termine di presentazione della domanda: 13 ottobre 2017. Il Concorso Travel Video Contest 2017, lanciato da InternationalStudent.com, invita a girare
Leggi tuttoFutureLab Europe 2018
Termine di presentazione della domanda: 24 settembre 2017. Il programma FutureLab Europe offre a giovani europei la possibilità
Leggi tuttoLingue, amore e concorsi
La Giornata Europea delle Lingue, istituita nel 2001 dal Consiglio d’Europa e dall’Unione europea, celebra le
Leggi tuttoStartupper nel mondo: L’innovazione che parla italiano
Termine di presentazione della domanda: 15 ottobre 2017. Il Ministero degli affari esteri e della cooperazione
Leggi tuttoAltiero Spinelli: Spreading knowledge about Europe
Termine di presentazione della domanda: 2 ottobre 2017. Il premio Altiero Spinelli Prize for Outreach: Spreading
Leggi tutto1 concorso video e 3 concorsi fotografici per volare a Bruxelles, Bonn o Strasburgo
L’Agenzia Europea per l’Ambiente (EEA) ha lanciato il concorso fotografico NATURE@work: scegli una città europea per raccontarne una storia
Leggi tuttoPremio per giovani esperti digitali
Termine di presentazione della domanda: 15 luglio 2017. Il premio European Youth Award (EYA) promuove studenti
Leggi tuttoFotografa la tua formazione professionale per l’Europa
Termine di presentazione della domanda: 15 luglio 2017. Il CEDEFOP, Centro Europeo per lo Sviluppo della Formazione
Leggi tuttoCan you do it in 90 seconds? DepicT 2017!
Termine di presentazione della domanda: 3 luglio 2017. Per chi ama filmare video molto corti ci sono l’Encounters
Leggi tuttoGiovani artisti visivi a Londra per 1 mese
Termine di presentazione della domanda: 30 aprile 2017. La società di gestione di appartamenti vacanze Art Apartments offre a
Leggi tuttoAmnesty International per cantanti under 35
Termine di presentazione della domanda: 22 aprile 2017. Il concorso “Voci per la Libertà – Una Canzone
Leggi tuttoArtisti nel mondo con Movin’Up
Termine per presentare la domanda: 1° marzo 2017. Il concorso Movin’Up, nell’ambito del progetto DE.MO. – sostegno
Leggi tuttoCineasti del domani a Fest!
Termine di presentazione della domanda: 28 febbraio 2017. Dal 19 al 26 giugno 2017, a Espinho, in
Leggi tuttoPremio europeo Carlo Magno della gioventù 2017
Termine di presentazione della domanda: 30 gennaio 2017 Hai tra i 16 e i 30 anni? Hai un’idea
Leggi tuttoWE_Welcome Europe
Termine di presentazione della domanda: 17 febbraio 2017. Il ministero dell’Istruzione, dell’università e della ricerca in
Leggi tutto#ThisIsMy5
Termine di presentazione della domanda: 31 gennaio 2017. Per l’anniversario del centro per i visitatori del
Leggi tuttoI giovani e le scienze 2017
Termine di presentazione della domanda: 10 febbraio 2017 La selezione italiana per il concorso dell’Unione europea concorso
Leggi tuttoYO!Fest 2017 – Let’s YouthUP Europe!
Termine della presentazione della domanda: 4 gennaio 2017. YO!Fest 2017 è il festival che vuole mobilitare giovani
Leggi tuttoConcorso internazionale di scrittura sul clima
Termine di presentazione della domanda: 15 dicembre 2016. L’organizzazione del Regno Unito Living Rainforest lancia il concorso di
Leggi tuttoMedia educativi per volare a Bruxelles
Termine di presentazione della domanda: 1 dicembre 2016. I premi MEDEA incoraggiano l’innovazione e le buone
Leggi tuttoMedea Awards 2017
Termine di presentazione della domanda: 1 dicembre 2016. I premi MEDEA promuovono l’innovazione e le buone
Leggi tuttoConcorso Juvenes Translatores per le scuole
Giorno della prova: 21 novembre 2016 La Commissione Europea promuove il concorso di traduzione Juvenes Translatores per le scuole europee
Leggi tuttoIl potenziale immaginativo e ispiratore dello spazio
Termine di presentazione della domanda: 30 settembre 2016. Il concorso di Education YiSS – Youth ISS
Leggi tuttoGira un video e vola in Francia
Termine di presentazione della domanda: 3 settembre 2016. L’EVS film festival è il concorso video europeo sulla cittadinanza
Leggi tuttoShining Stars of Europe 2016
Termine di presentazione della domanda: 18 settembre 2016. Pensa a un’idea per connetterti con i tuoi pari, l’ambiente e te
Leggi tuttoPremio della Società Civile del Comitato Europeo Economico e Sociale
Termine di presentazione della domanda: 9 settembre 2016. Il tema del premio 2016 è: Migranti. Il
Leggi tuttoConcorso fotografico Europe in my Region
Termine di presentazione della domanda: 28 agosto 2016. La Direzione Generale per le Politiche Regionali della Commissione
Leggi tuttoConcorso video-fotografico #BeActive
Termine per la presentazione della domanda: 27 agosto 2016. Dal 10 al 17 settembre 2016 in
Leggi tuttoGira un video sul cambiamento climatico e vola in Marocco
Termine di presentazione della domanda: 19 agosto 2016. tvebiomovies è un concorso video internazionale per giovani
Leggi tuttoConcorso di componimento per la Settimana europea delle PMI
Termine di presentazione della domanda: 2 settembre 2016. La Settimana europea delle PMI è un progetto annuale
Leggi tuttoMy city, il concorso fotografico dell’Agenzia europea per l’ambiente
Termine di presentazione della domanda: 15 agosto 2016. Il concorso fotografico My city promosso dall’Agenzia Europea
Leggi tuttoHai fatto l’Erasmus e ti piace scrivere? Racconta com’è andata al Taormina international book festival
Termine per la presentazione della domanda: 31 luglio 2016. Hai partecipato a un progetto di mobilità in
Leggi tuttoEuropean Youth Award
Termine di presentazione della domanda: 15 luglio 2016. Il premio European Youth Award (EYA) invita i giovani
Leggi tuttoConcorso cinematografico internazionale Nature Film Festival
Termine per la presentazione della domanda: 15 luglio 2016. Il concorso cinematografico internazionale Nature Film Festival di Innsbruck
Leggi tuttoNuova generazione di giornalisti scientifici
Termine per la presentazione della domanda: 14 luglio 2016. L’Unione di associazioni di giornalisti scientifici dell’Unione
Leggi tuttoCan you do it in 90 seconds? Partecipa a Depict! 2016
Termine di presentazione della domanda: 4 luglio 2016. Dimostra il tuo talento durante l’Encounters Short Film & Animation
Leggi tuttoConcorso fotografico Immagina l’Europa senza frontiere
Termine di presentazione della domanda: 30 giugno 2016. Il Gruppo Socialista Europeo nel Comitato delle Regioni
Leggi tuttoPremio James Dyson
Termine per la presentazione della domanda: 19 luglio 2016. Il concorso internazionale di progettazione, promosso dalla
Leggi tuttoPlural+ il festival video per cambiare il mondo
Termine di presentazione della domanda: 29 maggio 2016. Il festival PLURAL+ è una piattaforma su cui i
Leggi tuttoGiovani economisti scrittori
Termine di presentazione della domanda: 1 giugno 2016. L’Organizzazione Mondiale del Commercio (World Trade Organization) ha
Leggi tuttoBorse di studio per la Germania
Termine per la presentazione della domanda: 24 maggio 2016. Hai meno di 32 anni, sei iscritto a un Master
Leggi tuttoGiovani Talenti in Europa 2016
Termine di presentazione della domanda: 14 maggio 2016. Hai tra i 18 e i 35 anni?
Leggi tuttoGoogle Science Fair 2016
Termine di presentazione della domanda: : 18 maggio 2016. Il concorso scientifico online di Google, con
Leggi tuttoSea Of Words
Termine di presentazione della domanda: 2 giugno 2016. La Anna Lindh Foundation e l’Istituto Europeo del
Leggi tuttoYouth Citizen Entrepreneurship Competition
Termine di presentazione della domanda: 30 giugno 2016. Giovani imprenditori tra i 15 e i 25
Leggi tuttoConcorso di scrittura Goi peace 2016
Termine di presentazione della domanda: 15 giugno 2016. Hai meno di 25 anni, ti piace scrivere
Leggi tuttoSoluzioni energetiche per girare intorno al mondo
Termine di scadenza per la presentazione della domanda: 15 Aprile 2016. La 6° edizione della competizione tra
Leggi tuttoConcorso Europa e Giovani 2016
Termine di presentazione della domanda: 26 marzo 2016. Al concorso bandito dall’Istituto Regionale di Studi Europei
Leggi tuttoI giovani e le scienze 2016
Termine di presentazione della domanda: 24 febbraio 2016 Il concorso dell’unione europea I giovani e le scienze
Leggi tuttoPremio europeo Carlo Magno della gioventù 2016
Termine di presentazione della domanda: 25 gennaio 2016 Hai tra i 16 e i 30 anni? Proponi
Leggi tuttoConcorso fotografico “What does science mean to you?”
Termine di presentazione della domanda: il 15 di ogni mese 2015. Cosa significa per te la scienza?
Leggi tuttoMedia e Medea in concorso
Termine di presentazione della domanda: 30 novembre 2015. I premi MEDEA incoraggiano l’innovazione e le buone
Leggi tuttoCittà sostenibili nelle penne dei giovani
Termine di presentazione della domanda: 15 dicembre 2015. L’organizzazione del Regno Unito Living Rainforest ha lanciato un
Leggi tuttoConcorso fotografico mensile “BE OUR GUEST PHOTOGRAPHER!”
Ogni mese dell’anno 2015 il progetto propone un tema di grande importanza e impatto all’interno della
Leggi tuttoConcorso Juvenes Translatores per le scuole
Termine della presentazione della domanda: 20 novembre 2015 La Commissione Europea promuove il concorso Juvenes Translatores per le scuole
Leggi tuttoConcorso La scienza secondo me
Termine di presentazione della domanda: 10 ottobre 2015. L’Associazione SEA (Storytelling European Association), in collaborazione con il
Leggi tuttoShining Stars of Europe
Termine di presentazione della domanda: 30 settembre 2015 La 4° edizione del concorso ti invita a girare un
Leggi tuttoConcorso Europass un ponte per l’Europa
Termine di presentazione della domanda: 31 ottobre 2015. Il Centro Nazionale Europass (NEC) italiano invita gli
Leggi tuttoBlooom Award per giovani artisti
Termine di presentazione della domanda: 31 luglio 2015. Il concorso Blooom Award, promosso dalla storica birreria
Leggi tuttoDepicT!: concorso internazionale per cortometraggi
Termine di presentazione della domanda: 6 luglio 2015. Dimostra il tuo talento durante l’Encounters Short Film &
Leggi tuttoXVII Concorso Movin’ up per giovani creativi
Termine di presentazione della domanda: 30 giugno 2015. Movin’ Up è un bando rivolto ai giovani
Leggi tuttoConcorso di scrittura Goi peace
Termine di presentazione della domanda: 15 giugno 2015. Hai meno di 25 anni, ti piace scrivere
Leggi tuttoConcorso video PLURAL+
Termine di presentazione della domanda: 15 giugno 2015. Hai tra i 9 e i 25 anni? Partecipa
Leggi tuttoConcorso per il logo del 150° anniversario Giappone-Italia
Termine di presentazione della domanda: 30 giugno 2015. Nel 2016 Giappone e Italia celebrano il 150° anniversario
Leggi tuttoInnova, connetti e trasforma a Lisbona
Termine di scadenza per la presentazione della domanda: 31 maggio 2015. Sei un ricercatore o un innovatore?
Leggi tuttoPremio Young Audiences Music Awards (YAMA)
Termine di presentazione della scadenza: 1 giugno 2015. Il Premio Young Audiences Music Awards (YAMA) è
Leggi tuttoConcorso Game concept award – BAFTA YGD (Young Game Designers)
Termine di presentazione della domanda: giugno 2015 Sei appassionato di videogiochi? Giochi e pensi che vorresti
Leggi tuttoConcorso internazionale di racconti
Termine di scadenza della domanda: 31 maggio 2015. La Anna Lindh Foundation e l’Istituto Europeo del
Leggi tuttoConcorso Game making award – BAFTA YGD (Young Game Designers)
Termine di presentazione della domanda: 1 giugno 2015. Sei appassionato di videogiochi? Ti piace programmare e conosci la
Leggi tuttoConcorso #Ideegiovani
Termine di presentazione della domanda: 20 aprile 2015. Hai meno di 30 anni? Partecipa al concorso #Ideegiovani e
Leggi tuttoConcorso Gender Equality: picture it!
Termine di presentazione della domanda: 20 aprile 2015. Per celebrare il 20° anniversario della 4° Conferenza mondiale delle
Leggi tuttoConcorso Diventare Cittadini Europei
Termine di presentazione della domanda: 18 aprile 2015. L’Associazione Italiana per il Consiglio dei Comuni e
Leggi tuttoConcorso “60 Anni dopo Messina: dare nuovo slancio all’Europa”
Termine di presentazione della domanda: 18 aprile 2015. Sharing Messina Ideal a Lesson for all Europe
Leggi tuttoFiera della Scienza di Google 2015
Termine di presentazione della domanda: 18 maggio 2015. Hai tra i 13 e i 18 anni?
Leggi tuttoConcorso video Build Europe with us!
Termine di presentazione della domanda: 18 maggio 2015. Con questo concorso video la Commissione europea vuole coinvolgere i giovani a
Leggi tuttoConcorso fotografico Our Future is on the Table!
Termine di presentazione della domanda: 10 aprile 2015. Se hai tra i 15 e i 25
Leggi tuttoConcorso fotografico sul Giappone
Termine di presentazione della domanda: 5 maggio 2015. Wa!Japan Film Festival, uno dei più grandi festival di fotografia,
Leggi tuttoConcorso Radio24 Giovani Talenti in Europa
Termine di partecipazione: 16 maggio 2015. Hai tra i 18 e i 40 anni, ti piace
Leggi tuttoProgramma JM Jazz World Orchestra
Termine di presentazione della domanda: : 16 marzo 2015. La Jeunesses Musicales International offre l’opportunità a
Leggi tuttoConcorso twitter del Global Education First Initiative (GEFI)
Termine di presentazione della domanda: 6 marzo 2015. Hai qualche idea per lo slogan del GEFI al
Leggi tuttoMediterranea 17 Young Artists Biennale
Termine di presentazione della domanda: 15 marzo 2015 “Mediterranea 17 Young Artists Biennale” è un
Leggi tuttoConcorso di scrittura Amazon
Termine di presentazione della domanda: 28 febbraio 2015 Il concorso è organizzato e condotto da Amazon Media EU in occasione del Festival
Leggi tuttoConcorso di scrittura “So similar, so different, so European”
Termine di presentazione della domanda: 27 febbraio 2015 Hai tra i 18 e i 25 anni e
Leggi tuttoPremio europeo Carlo Magno della gioventù 2015
Termine di presentazione della domanda: 2 febbraio 2015 Hai tra i 16 e i 30
Leggi tuttoConcorso internazionale di componimento e dibattito per le scuole
Termine di presentazione della domanda: 1 febbraio 2015 Hai tra i 7 e i 17 anni e
Leggi tuttoConcorso Cartier Women’s Initiative
Termine di presentazione della domanda: 27 febbraio 2015 La competizione internazionale sostiene e incoraggia l’imprenditorialità femminile:
Leggi tuttoCosì simili, così diversi, così europei
Termine di presentazione della domanda: 27 febbraio 2015 “Così simili, così diversi, così europei” è
Leggi tuttoI giovani e le scienze 2015
Termine di presentazione della domanda: 25 febbraio 2015 Sei frequenti le scuole secondarie di 2° grado,
Leggi tuttoRiprenditi la città, Riprendi la luce
Scadenza: 28 febbraio 2015 Il concorso video “Riprenditi la città, Riprendi la luce” vuole sensibilizzare i
Leggi tuttoBehave – residenze per artisti in Lussemburgo
Termine di presentazione della domanda: 23 gennaio 2015 Public Art Experience ha lanciato BeHave, il suo primo
Leggi tuttoConcorso TELL US
Termine di presentazione della domanda: 31 gennaio 2015 TELL US è un concorso promosso dalla
Leggi tuttoConcorso internazionale ClimaSouth
Termine di presentazione della domanda: 15 gennaio 2015 Ti stai facendo domande sull’autunno più caldo
Leggi tuttoBerlin wants young photojournalists
Termine di presentazione della domanda: 9 gennaio 2015 Hai tra i 20 e i 25
Leggi tutto